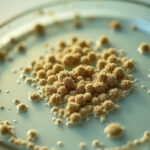

Author Archives: admin - Page 33
Esperan 48 frentes fríos en Chihuahua en la temporada invernal
Chihuahua se alista para una temporada invernal con 48 frentes fríos Noticias de Chihuahua El estado de Chihuahua se prepara para enfrentar una temporada invernal más intensa de lo habitual,…
Luis Balderrama destaca en Phoenix con victoria en 190 libras
Luis Balderrama de Nuevo Casas Grandes gana en torneo amateur en Phoenix Noticias de Chihuahua El joven boxeador Luis Balderrama, originario de Nuevo Casas Grandes y representante del gimnasio Old…
Chihuahua cierra la semana con 20 muertes por sarampión
Aumentan contagios y muertes por sarampión en Chihuahua Noticias de Chihuahua El estado de Chihuahua cerró la semana con un panorama alarmante: 20 muertes confirmadas por sarampión, además de un…
Usuarios deberán fijar límite en banca digital desde octubre 2025
Bancos asignarán límite automático si no configuras tu MTU en 2025 Noticias de Chihuahua A partir del 1 de octubre de 2025, todos los usuarios de banca digital en México…
Los secretos para construir confianza en ti mismo
Tips para desarrollar seguridad y confianza en ti mismo Noticias de Chihuahua La confianza en uno mismo no es un regalo con el que se nace, sino una habilidad que…
¿Por qué los arándanos son considerados un superalimento?
Beneficios de los arándanos y su poder como superalimento Noticias de Chihuahua En los últimos años, los arándanos se han ganado un lugar privilegiado en la mesa de muchas familias…
Qué hacer y qué no hacer al visitar zonas arqueológicas
Consejos para visitar zonas arqueológicas con respeto y cuidado Noticias de Chihuahua México es un país privilegiado por su enorme riqueza cultural y su legado histórico. Desde Paquimé en Casas…
Astrónomos descubren un puente cósmico que conecta dos galaxias enanas
Detectan puente colosal de hidrógeno entre dos galaxias enanas Noticias de Chihuahua Un equipo internacional de astrónomos anunció el hallazgo de un puente cósmico colosal formado por hidrógeno neutro, que…
Un día como hoy Alexander Fleming descubrió la penicilina en 1928
Fleming descubrió la penicilina un 28 de septiembre de 1928 Noticias de Chihuahua Un 28 de septiembre de 1928, el científico escocés Alexander Fleming realizó un hallazgo que cambiaría para…
Carreteras de Chihuahua tendrán mantenimiento: Sheinbaum
Claudia Sheinbaum anuncia programa permanente de reparación de carreteras en Chihuahua Noticias de Chihuahua En su más reciente visita a Ciudad Juárez, la presidenta de México, Claudia Sheinbaum, anunció el…